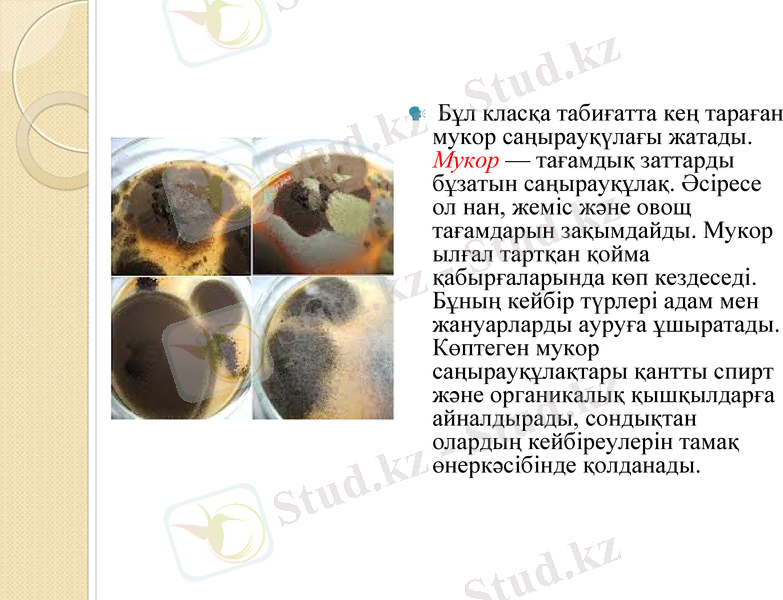
Slide 13

Саңырауқұлақтар мен қарапайымдылардың морфологиясы, физиологиясы және патологиясы



ПРЕЗЕНТАЦИЯ
Тақырыбы: Саңырауқұлақтар мен қарапайымдылардың морфологиясы мен физиологиясы.
Орындаған: Примжарова Д. А
Тобы: ЖМҚА-07-20
Қабылдаған:
Шымкент 2021

Жоспар
I. Кіріспе
II. Негізгі бөлім
1. Саңырауқұлақтардың жіктелуі.
2. Саңырауқұлақтар мен қарапайымдылардың морфологиясы мен физиологиясы.
3. Адам ауруын тудыратын қарапайымдылардың түрлері.
4. Микоздар.
III. Қорытынды
IV. Қолданылған әдебиеттер тізімі

Кіріспе
Саңырауқұлақтар - эукариотты организмдердің ішінде ең ежелгісі және олардың өсімдіктер мен жануарларға тән белгілері бар. Олар өсімдіктер сияқты шектелмеген, апикалды өседі және клетка қабықшасы қатты. Жануар клеткасына ұқсастығы - фототүзуші пигмент - хлорофил болмайды, қоректенуі бойынша - гетеротрофты. Клетка қабықшасында хитин бар.

Саңырауқұлақтың құрылысы
Санырауқұлақ денесі (таллом-қабықшалар) мицелий (грибница) болып табылады. Олар перделері бар немесе жок, бұтақша жайылган түтікшелер тәрізді, және де бүршiктенген оваль, дөнгелекше пішінді жасушалардан тұратын гифалар.
Құрылымына байланысты
1. Гифалылар немесе мицелийлілер (зен саныраукұлақтар)
2. Бүршіктенушiлер (ашыткылар, ашыткытәріздестер) .
Ен кыска мицелийлер-ашыткыларда; ең ұзыны-көгерткіш саныраукұлақтарда (мукорларда) .


Саңырауқұлақтардың көбеюі
Саңырауқұлақтар 3 түрлі жолмен көбейеді: вегетативті, жынысты және жыныссыз.
Вегетативті көбею.
Мицелиялардың бөліктері арқылы немесе - гифтердің бөлшектенуі нәтижесінде пайда болатын, жекелеген клеткалар және хламидоспоралар - қоршаған ортаның қолайсыз жағдайларына төзімді, қалың қабырғалы клеткалар арқылы жүзеге асырылады. Оидия мен хламидоспоралар жоғары сатыдағы саңырауқұлақтарға тән. (Сүр. 1 )
Сүрет 1. Жоғары сатыдағы саңырауқұлақтардың құрылысы:
а) оидиялар, б) хламидоспоралар.

Жыныссыз спора арқылы көбею.
Бұл жағдайда саңырауқұлақтардың вегетативті көбеюінің белгілі бір кезеңінде мицелиялардың арнайы ұрық тасымалдаушы гифтері түзіледі.
Төменгі сүрет. 2 саңырауқұлақтарда спора шар тәрізді қапшықта пайда болады, оны спорангилер деп атайды, яғни спора соның ішінде өнеді (эндоспоралар) .
Ұрық тасымалдаушы гифте өнетін спорангиді - споратасымалдаушы деп атайды
б) а)
Сурет 2. Ұрық тасымалдаушы гифтердің құрылысы: а) Споратасымалдаушы б) конидиятасымалдаушы
Споралардың сақина түзуін конидия деп атайды. Конидияда орналасқан споралар ұрық тасымалдаушы гифтердің сыртында орналасқан (экзоспоралар) .
Ұрық тасымалдаушы гифте түзілетін конидияларды конидиятасымалдаушы деп атайды.

Жынысты көбею.
Жынысты көбею (митоз) екі бірнеше ядролы мицелия гифтерінің қосылуынан басталады.
Жынысты көбею 3 сатыдан тұрады:
Плазмогамия - екі протопласт гиферінің қосылуы; нәтежиесінде клеткада 2 ядро пайда болады, оны дикарион деп атайды.
Кариогамия - екі гаплоидты ядролардың қосылуы (қос жинақты хоромосомасы бар ядро) .
Мейоз - реттік бөліну; ядроның бөлінуі бірнеше стадиядан тұрады.
Саңырауқұлақтар гомо- және гетероталшықты болып бөлінеді. Гомоталшықты саңырауқұлақтардың ұқсас гифтері қосылады, ал гетероталшықты ұрықтану әртүрлі жынысты мицелиялардың арасында жүреді.
Кейбір саңырауқұлақтар жынысты жолмен көбейе алмайды. Оларды жетілмеген саңырауқұлақтар деп атайды.

Саңырауқұлақтар
Саңырауқұлақтар аэробты организмдер. Сондықтан олар қоректік заттардың бетінде колония құрып тіршілік етеді.
Сыртқы орта жағдайларына саңырауқұлақтар төзімді организмдер. Төменгі температура, тұздың едәуір концентрациясы және ортаның қышқылдығы аса әсер ете қоймайды. Сондықтан саңырауқұлақтар іс жүзінде барлық жерлерде кездеседі.


Морфологиялық және физиологиялық қасиеттеріне қарай саңырауқұлақтарды негізгі бес класқа бөлуге болады.

Архимицеттер - бұлардың ерекшелігі сол, мицелийі болмайды, болса да ол нашар жетілген, 300-ден астам түрі бар. Көбінесе жыныссыз жолмен көбейеді. Споралары спорангийде түзіледі. Бұл саңыраукұлактардың бірқатары жоғары және төменгі сатыдағы өсімдіктерді закымдайды.
Фикомицеттер -Мицелийі жақсы жетілген бір клеткалы саңырауқұлақтар, жынысты және жыныссыз жолдармен көбейеді. Жыныссыз жолмен көбейгенде спорангийде споралар түзіледі, ал жынысты жолмен кәбейгенде зооспоралар пайда болады, оның 700-ге жуық түрі бар.
Бұл класқа табиғатта кең тараған мукор саңырауқүлағы жатады. Мукор - тағамдық заттарды бұзатын саңырауқұлақ. Әсіресе ол нан, жеміс және овощ тағамдарын зақымдайды. Мукор ылғал тартқан қойма қабырғаларында көп кездеседі. Бұның кейбір түрлері адам мен жануарларды ауруға ұшыратады. Көптеген мукор саңырауқұлақтары қантты спирт және органикалық қышқылдарға айналдырады, сондықтан олардың кейбіреулерін тамақ өнеркәсібінде қолданады.

Аскомицеттер - бұлардың көп клеткалы мицелийлері бар. Олардың көпшілігі мәдени өсімдіктерді және түрлі тағамдарды бүлдіреді.
Аспергиллус (қара зең) . Жануар және өсімдік тектес тағамдарды бүлдіреді. Аспергиллустың кейбір түрлері лимон қышқылы, ферменттерді алуда, спирт өндіруде солод ретінде қолданылады. Солод деп өндірілген дәндерді айтады. Әсіресе ол сыра кайнатуда жиі қолданылады.
Пенициллум (к ө к-ж а с ы л з е ң) . Конидии споралары қолдың саусағындай тарамдалып келген. Ол көптеген тағамдық заттарды бүлдіреді. Үйлердің ылғал тартқан қабырғаларынан да бұларды көп кездестіруге болады.
Пенициллумнің кейбір түрлері пенициллин деп аталатын дәріні алу ушін қолданылады.
Склеротиния - ақ түсті шіріктің жеміс және овощтарда кездесуі осы склеротинияға байланысты. Мұның мицелийі зақымдаған затына еніп, онда ақ түсті мақта тәрізденген шоғыр дене түзеді.

Фузариум негізінен астық тұқымдастарды, жемістерді және көкөністерді зақымдайды. Осы саңырауқұлақ қоздыратын ауруды фузариоз деп атайды. Ол өсімдіктердің тамыры мен сабағын бүлдіреді, соның салдарынан өсімдіктер қурап қалады. Фузариоз ауруына шалдыққан дәннен жасалған нанды пайдалануға болмайды. Одан адам уланып қалуы мүмкін.
Ботритис - пияздың және капуста, помидорлардың шіруіне себепші болатын саңырауқұлақ. Мұнымен кейде жеміс-жидектер де зақымдалады. Альтернария сәбіз, аскөк т. б. сияқты тамыржемістілерді зақымдап, оларды шірітіп жібереді.
Жетілмеген саңырауқұлақтар

Ашытқы саңырауқұлақтары - бір клеткалы қозғалмайтын және бактериялардан шамамен алғанда он еседей ірі микроорганизмдер. Табиғатта бұлар кең тараған. Клетка пішіні әр түрлі: дөңгелек, сопақша және таяқша тәрізді болады.
Ашытқы саңырауқұлақтары клеткасының мөлшері 8-10 микронға тең. Оларда қозғалу органеллалары болмайды. Клетка сыртында қабығы бар. Цитоплазмада ядро, вакуоль және басқа да (май, гликоген, волютин) заттар кездеседі. Ашытқы саңырауқұлақтарын адам баласы қолдан өсіріп, өз шаруашылығында пайдаланады.
Ашытқы саңырауқұлақтары

Сахаромицеттер. Бұларға мәдени ашытқы саңырауқұлақтар жатады. Олар бүршіктену және споралар түзу арқылы көбейеді. Сондықтан бұларды нағыз ашытқы саңырауқұлақтар деп атайды. Мәдени ашытқы саңырауқұлақтарға нан, шарап, сыра ашытқы саңырауқұлақтары жатады.
,

Қарапайымдылар
Қарапайымдыларда қозғалу (талшықтар, кірпікшелер, жалған аяқтар), қоректену (ас қорыту вакуольдері) және шығару (жиырылғыш вакуольдер) мүшелері бар.
Қоректену түрі бойынша олар гетеротрофтар немесе аутотрофтар болуы мумкін. Жыныссыз және жыныстык жолмен көбейеді. Қарапайымдылардың кейбір түрлерінде жыныстык және жыныссыз көбею алмасып отыратын күрделі - циклі болады, олар циста тузеді.

Қарапайымдылар 7 типке бөлінеді, сонын iшiнде төртеуi адамдарда ауру қоздырады.
Sarcomastigophora muni - Sarcodina және Mastigophora типшесiнен тұрады.
Sarcodina тип (саркадалылар) - еркін тірші ететін амебалар (негперия, акантамеба және т. б. туыстастыктар) және патогенсіз амебалар (ішек амеба т. б. ) жатады. Бұл қарапайымдылар жалған аяктар (псевдоподий) түзіп қозғалады, олардың көмегімен қоректік заттар ұсталып жасуша цитоплазмасына енедi. Амебалар жынысты жолмен көбеймейдi. Қолайсыз жағдайда олар циста түзедi.
Mastigophora типшесiнiн (талшық тасымалдаушы) патогендi өкiлдері ба мысалы: трипаносомалар-африкалық трипаносомоз (ұйкы ауруы) және Шагас аурулары қоздырғыштары; лейшманиялар-терi және висцеральды лейшманиоз;

Apicomplexa muni. Sporozoa (споровиктер) класынын патогендi өкілдеріне безгек плазмодийлері токсоплазмалар, саркоцисталар, изоспоралар, криптоспоралар, циклоспоралар, бабезийлер Паразиттердің апикальды кешені иесінің жасуша ішіне еніп әрі қарай жасушаішілік паразиттік тіршілік етуге мүмкіндік береді.
Ciliophora muni. Кірпікшелердiн патогенді өкіліне адамдардың тоқ ішегін зақымдайтын балантиди коздырғышы-Balantidium coli жатады.
- Іс жүргізу
- Автоматтандыру, Техника
- Алғашқы әскери дайындық
- Астрономия
- Ауыл шаруашылығы
- Банк ісі
- Бизнесті бағалау
- Биология
- Бухгалтерлік іс
- Валеология
- Ветеринария
- География
- Геология, Геофизика, Геодезия
- Дін
- Ет, сүт, шарап өнімдері
- Жалпы тарих
- Жер кадастрі, Жылжымайтын мүлік
- Журналистика
- Информатика
- Кеден ісі
- Маркетинг
- Математика, Геометрия
- Медицина
- Мемлекеттік басқару
- Менеджмент
- Мұнай, Газ
- Мұрағат ісі
- Мәдениеттану
- ОБЖ (Основы безопасности жизнедеятельности)
- Педагогика
- Полиграфия
- Психология
- Салық
- Саясаттану
- Сақтандыру
- Сертификаттау, стандарттау
- Социология, Демография
- Спорт
- Статистика
- Тілтану, Филология
- Тарихи тұлғалар
- Тау-кен ісі
- Транспорт
- Туризм
- Физика
- Философия
- Халықаралық қатынастар
- Химия
- Экология, Қоршаған ортаны қорғау
- Экономика
- Экономикалық география
- Электротехника
- Қазақстан тарихы
- Қаржы
- Құрылыс
- Құқық, Криминалистика
- Әдебиет
- Өнер, музыка
- Өнеркәсіп, Өндіріс
Қазақ тілінде жазылған рефераттар, курстық жұмыстар, дипломдық жұмыстар бойынша біздің қор #1 болып табылады.



Ақпарат
Қосымша
Email: info@stud.kz